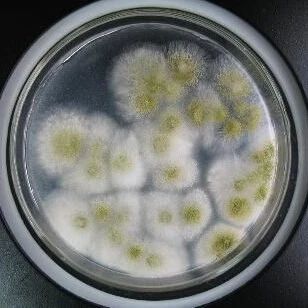

|
年终盘点:2018年细胞治疗重要研究盘点 Cell · 公众号 · 医学 · 6 年前 · |

|

|
Cell:人体细胞中发现抗埃博拉病毒蛋白 Cell · 公众号 · 医学 · 6 年前 · |

|

|
J Immunol:科学家们揭示NK细胞的起源机制 Cell · 公众号 · 医学 · 6 年前 · |

|

|
Sci Rep:科学家鉴别出参与T细胞激活的新分子 有望帮助开发新型癌症免疫疗法 Cell · 公众号 · 医学 · 6 年前 · |

|

|
基于扩增干细胞的脂肪填充术成为传统丰胸术的重要替代方案 Cell · 公众号 · 医学 · 6 年前 · |

|

|
《自然》评选2018年度十大科学人物 Cell · 公众号 · 医学 · 6 年前 · |

|

|
答复函到!国家卫健委将组织开展细胞治疗技术临床研究机构申报、遴选、备案 Cell · 公众号 · 医学 · 6 年前 · |

|

|
Cell:重大进展!三种脑细胞功能故障导致化疗脑 Cell · 公众号 · 医学 · 6 年前 · |

|

|
2018年度巨献:那些打破教科书挑战常规的突破性研究解读 Cell · 公众号 · 医学 · 6 年前 · |

|

|
浙江省人民政府发布文件:将开展细胞治疗技术创新发展试点! Cell · 公众号 · 医学 · 6 年前 · |

|

|
科学家发现第一次细胞命运决定的新模式 Cell · 公众号 · 医学 · 6 年前 · |

|

|
Cell Stem Cell:肠道或许还有造血功能!人类肠道可能提供了多达10%的血细胞 Cell · 公众号 · 医学 · 6 年前 · |

|

|
2018年度聚焦:艾滋病重磅级研究成果解读 Cell · 公众号 · 医学 · 6 年前 · |

|
|
|
Nature:利用单细胞谱系图谱追踪细胞直接重编程 Cell · 公众号 · 医学 · 6 年前 · |

|

|
吴开春教授丨如何看待干细胞移植和粪菌移植治疗炎症性肠病 Cell · 公众号 · 医学 · 6 年前 · |

|

|
美FDA批准首个异种皮肤移植试验:皮肤细胞来自转基因猪 Cell · 公众号 · 医学 · 6 年前 · |

|
|
污染的细胞:我觉得自己可以这么抢救 Cell · 公众号 · 医学 · 6 年前 · |

|

|
梅奥医学中心针对CAR-T细胞治疗的毒性和有效性的两大新策略 Cell · 公众号 · 医学 · 6 年前 · |

|

|
EJI:科学家鉴别出新型T细胞 有望帮助治疗癌症和自身免疫性疾病等多种疾病 Cell · 公众号 · 医学 · 6 年前 · |

|

|
AXL蛋白靶向药物有望提高CAR-T细胞疗法治疗B细胞血癌的反应率 Cell · 公众号 · 医学 · 6 年前 · |

|